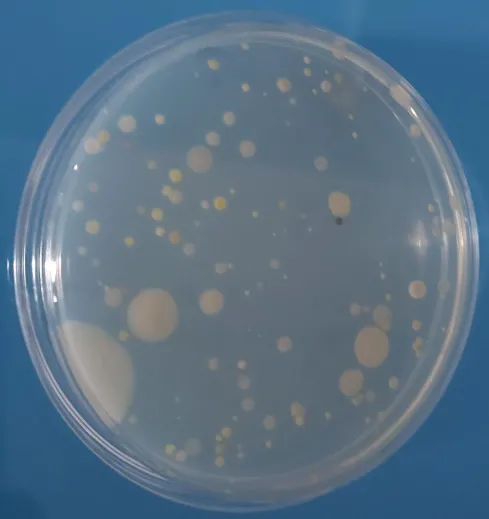
Adaptation microbienne

Adaptation microbienne
Nos principaux objectifs de recherche sont de comprendre comment les micro-organismes s'adaptent à différents changements métaboliques, cruciaux pour leur survie. Nos études portent sur la détection et la signalisation des différentes conditions gazeuses, la disponibilité des éléments constitutifs de l'ADN et les interactions réciproques de la réplication et de la réparation de l'ADN, responsables de la garantie de l'intégrité génomique dans des conditions extrêmes. Nous nous intéressons également à l'implication des structures inhabituelles de l'ADN/ARN dans des processus biologiques clés. Pour répondre à ces questions cruciales, nous utilisons un large éventail de méthodes expérimentales et informatiques.
------------------------------
Chercheurs / Enseignants-Chercheurs
Alexey ALEKSANDROV, CR, CNRS
Hubert BECKER, Pr, Sorbonne université (ORCID ID)
Stéphane DUIGOU, CR, CNRS
Lionel GUITTAT, MdC, Université Sorbonne Paris-Nord
Ursula LIEBL, DR, CNRS, Emeritat
Roxane LESTINI, Prof, Ecole Polytechnique
Jean-Louis MERGNY, DR, Inserm (ORCID ID)
Hannu MYLLYKALLIO, DR, CNRS
Stéphane SKOULOUBRIS, MdC, Univ. Paris–Saclay
Techniciens / Ingénieurs
Anne CUCCHIARINI, IE
Amandine IGNACE, AI, CNRS
Isabelle LAMARRE-JOUENNE, IEHC, Inserm
Caroline L'HERMITTE STEAD, AI, Inserm
Julien GROS, IR, X, CDD
Post-doctorant.e.s
Tom MARIOTTE
Suman PANDA
Dmitrii TRUBESTSKOY
Doctorant.e.s / Etudiant.e.s
Manon AGOSTINI (doctorante)
Elsa BALDUZZI (doctorante)
Yun CHEN (doctorant)
Giacomo FERRARI (doctorant)
Tom GARNIER (doctorant)
Maria IMEZAR (doctorante)
Adrien PARAVEL (doctorant)
Kate SORG (doctorante)
Wenlu YIN (doctorant)









